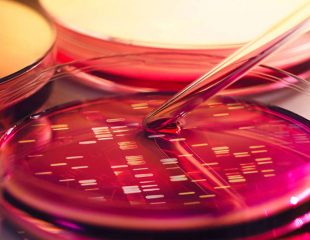

ژن

رژیم غذایی بر مبنای ژن های هوشمند
فلوید چیلتون پدیدآورنده این رژیم غذایی و دارای مدرک PhD و استاد فیزیولوژی دانشکده پزشکی ویک فارست میگوید ژن های ...
نسخه

ژن ها و وراثت
ژن ها و وراثت / ژن های والیدن به فرزندان به ارث می رسند و تا حدی ویژگی های جسمانی ...
نسخه

ژن های شایع ذکر شده در مطالعه اوتیسم
یکشنبه 20 ژوئیه 2014 (اخبار سلامت) – ژن های شایع ذکر شده در مطالعه اوتیسم با توجه به یک مطالعه جدید ...
نسخه

تست APOE و مشاوره ژنتیکی
تعریف کلمات کلیدی تست APOE و مشاوره ژنتیکی اَلِلْ ها: اشکال مختلف یک ژن است. 2 الل می تواند یک ژن ...
نسخه

ژن APOE و آلزایمر
خطر ژنتیک: ژن APOE و آلزایمر اغلب بیماری آلزایمر در سنین بالا بروز می کند. عمدتاً بعد از 65 سالگی ...
نسخه
ژن ها و آلزایمر : چه کسانی به آلزایمر مبتلا می شوند؟
ژن ها و آلزایمر : اما مطالعه دوقلوهای همسان نشان می دهد ژن ها عامل سرنوشت ساز نیستند. امکان دارد شما ...
نسخه
مطالب ویژه نسخه

مصرف بیش از حد این 8 ماده غذایی بینهایت خطرناک است

شیرین کننده مصنوعی چیست، فواید و مضرات آن کدام است؟

14 دلیلی که نشان میدهد چرا شما همیشه گرسنه هستید

قبل از اهدای خون چه چیزی بخوریم و چه چیزی نخوریم

چند نکته مهم در تعیین اهداف و رشد شخصی (بخش اول)
آخرین مطالب


لیست بهترین متخصص ارتودنسی در چیذر و نواحی اطراف آن


لیست متخصص ارتودنسی در دروس و اطراف آن

کلیه حقوق این وب سایت متعلق به وب سایت نسخه می باشد. طراحی وب سایت و سئو توسط استدیو نت ابزار



